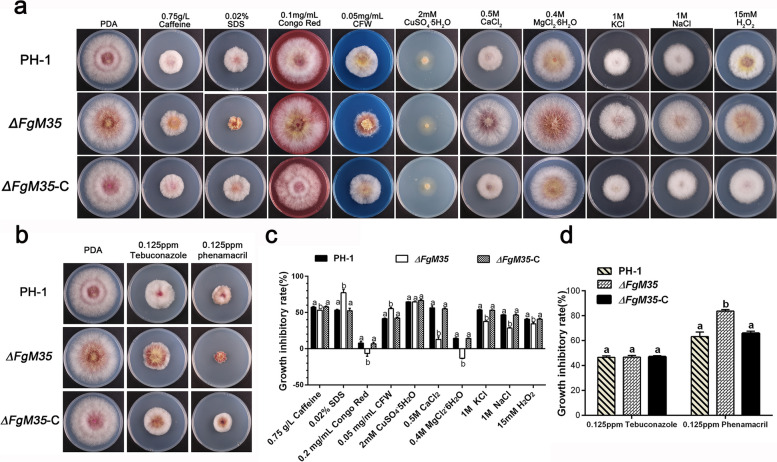
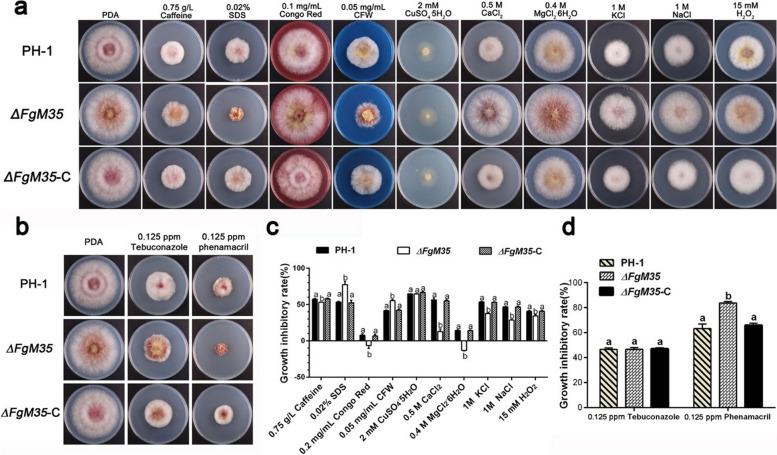

{"title":"更正:以小麦锌结合蛋白 TaZnBP 为靶标的锌金属蛋白酶 FgM35 对禾谷镰刀菌的毒力有促进作用。","authors":"Xin-Tong Wang, Kou-Han Liu, Ying Li, Yan-Yan Ren, Qiang Li, Bao-Tong Wang","doi":"10.1007/s44154-024-00200-x","DOIUrl":null,"url":null,"abstract":"","PeriodicalId":74874,"journal":{"name":"Stress biology","volume":"4 1","pages":"49"},"PeriodicalIF":5.8000,"publicationDate":"2024-11-27","publicationTypes":"Journal Article","fieldsOfStudy":null,"isOpenAccess":false,"openAccessPdf":"https://www.ncbi.nlm.nih.gov/pmc/articles/PMC11602883/pdf/","citationCount":"0","resultStr":"{\"title\":\"Correction: Zinc metalloprotease FgM35, which targets the wheat zinc-binding protein TaZnBP, contributes to the virulence of Fusarium graminearum.\",\"authors\":\"Xin-Tong Wang, Kou-Han Liu, Ying Li, Yan-Yan Ren, Qiang Li, Bao-Tong Wang\",\"doi\":\"10.1007/s44154-024-00200-x\",\"DOIUrl\":null,\"url\":null,\"abstract\":\"\",\"PeriodicalId\":74874,\"journal\":{\"name\":\"Stress biology\",\"volume\":\"4 1\",\"pages\":\"49\"},\"PeriodicalIF\":5.8000,\"publicationDate\":\"2024-11-27\",\"publicationTypes\":\"Journal Article\",\"fieldsOfStudy\":null,\"isOpenAccess\":false,\"openAccessPdf\":\"https://www.ncbi.nlm.nih.gov/pmc/articles/PMC11602883/pdf/\",\"citationCount\":\"0\",\"resultStr\":null,\"platform\":\"Semanticscholar\",\"paperid\":null,\"PeriodicalName\":\"Stress biology\",\"FirstCategoryId\":\"1085\",\"ListUrlMain\":\"https://doi.org/10.1007/s44154-024-00200-x\",\"RegionNum\":0,\"RegionCategory\":null,\"ArticlePicture\":[],\"TitleCN\":null,\"AbstractTextCN\":null,\"PMCID\":null,\"EPubDate\":\"\",\"PubModel\":\"\",\"JCR\":\"\",\"JCRName\":\"\",\"Score\":null,\"Total\":0}","platform":"Semanticscholar","paperid":null,"PeriodicalName":"Stress biology","FirstCategoryId":"1085","ListUrlMain":"https://doi.org/10.1007/s44154-024-00200-x","RegionNum":0,"RegionCategory":null,"ArticlePicture":[],"TitleCN":null,"AbstractTextCN":null,"PMCID":null,"EPubDate":"","PubModel":"","JCR":"","JCRName":"","Score":null,"Total":0}
引用次数: 0

求助内容:
求助内容: 应助结果提醒方式:
应助结果提醒方式:


